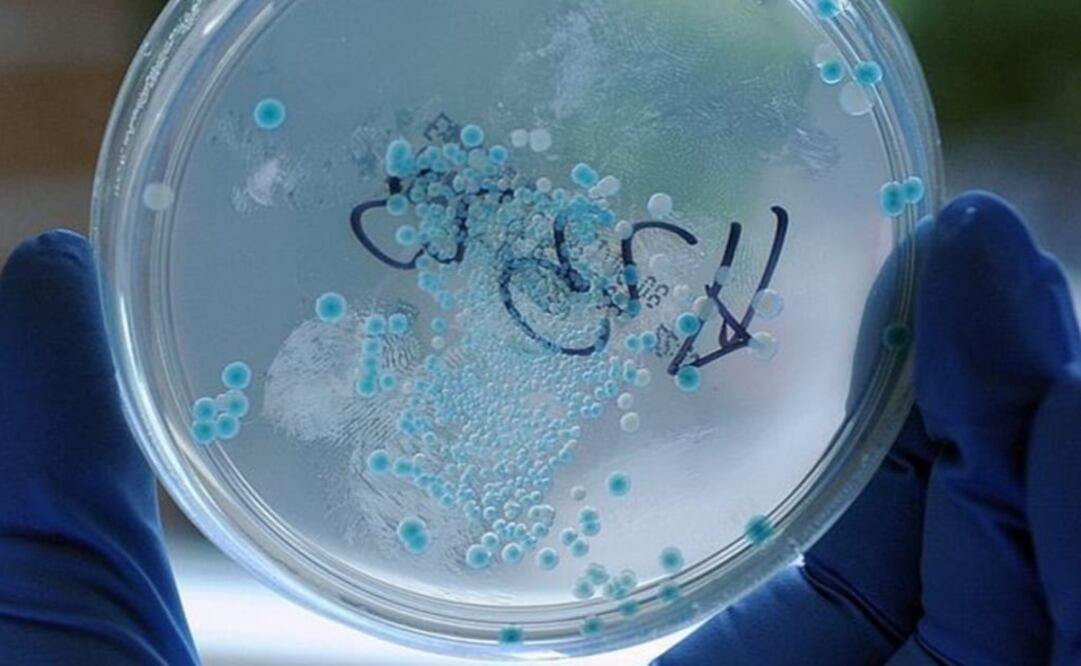
(FOTO: Especial)

Científicos de Estados Unidos anunciaron hoy el desarrollo del primer organismo semisintético "estable", un avance que podría tener importantes implicaciones para la medicina e incluso podría preparar el terreno para la creación de nuevas formas de vida.
"Hicimos este organismo semisintético más parecido a la vida", dijo en una declaración el autor principal, Floyd Romesberg, profesor del Instituto de Investigación Scripps. Toda la vida en la Tierra es construida a partir de cuatro bases naturales llamadas A, T, C y G, pero en el 2014, Romesberg y sus colegas ampliaron el código genético de la vida de cuatro a seis letras, agregando dos bases sintéticas llamadas X y Y al ADN de la bacteria Escherichia coli.
Pero el organismo semisintético resultante crecía con lentitud y no podía mantener el par de base sintético de forma indefinida en su código a medida que se dividía. En el nuevo estudio, los investigadores optimizaron una herramienta llamada transportador nucleótido con lo que fue mucho más fácil para el organismo semisintético crecer y dividirse y a la vez conservar la X y la Y.
Los investigadores describieron además en la revista estadounidense Proceedings of the National Academy of Sciences cómo mejoraron su versión previa de Y. Romesberg subrayó que su trabajo es sólo en organismos unicelulares y no busca usarse en organismos más complejos y agregó que las aplicaciones reales de este organismo semisintético son "cero" en este momento.
jpe
Noticias según tus intereses
[Publicidad]
[Publicidad]